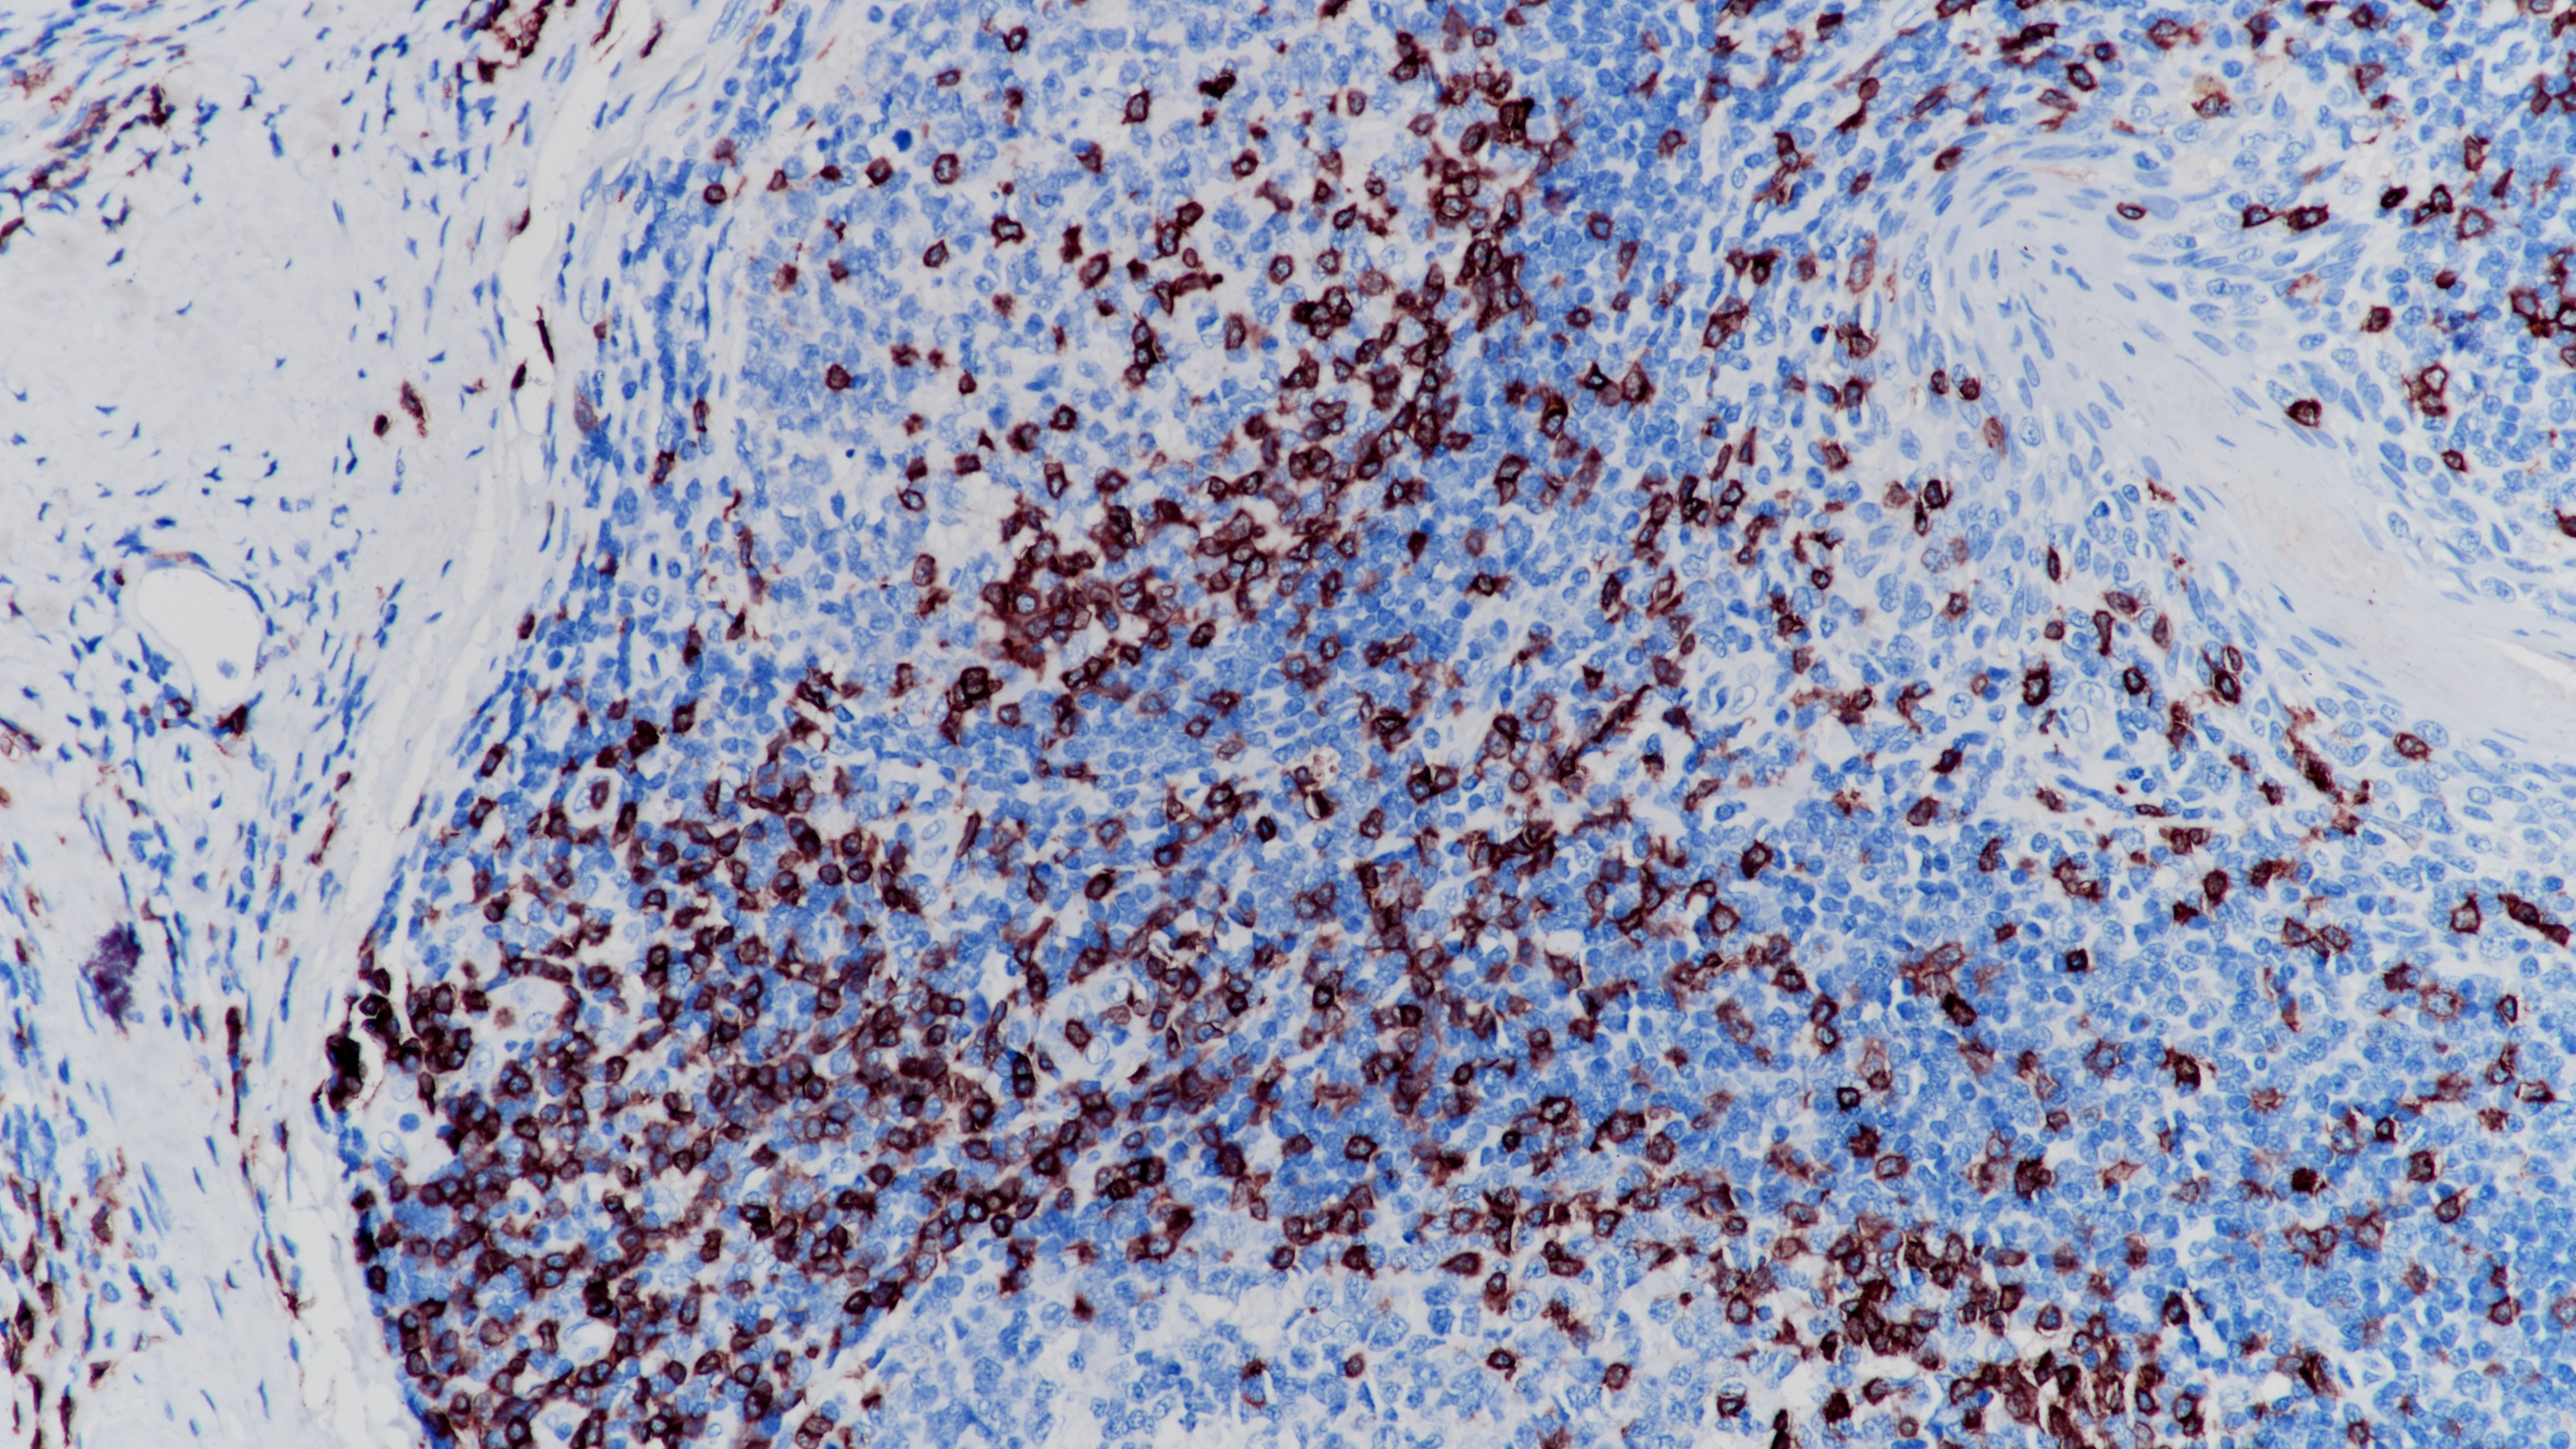
扁桃体CD3(BP6039)染色

1. Campana D, et al. The cytoplasmic expression of CD3 antigens in normal and malignant cells of the T lymphoid lineage. J Immunol. 1987 Jan; 138(2):648-55.
2. Steward M, et al. Production and characterization of a new monoclonal antibody effective in recognizing the CD3 T-cell associated antigen in formalin-fixed embedded tissue. Histopathology. 1997 Jan; 30(1):16-22.
3. 中华医学会.《临床技术操作规范·病理学分册》.人民军医出版社,2004.